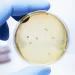

Les probiotiques
Les probiotiques : c’est quoi au juste ?
Il a fallu attendre le 21e siècle pour qu’ils aient leur définition « officielle ». Pourtant, la consommation de ces micro-organismes bienfaisants remonte à la nuit des temps.
- Comprendre les microbiotes
- Microbiote et troubles associés
- Agir sur nos microbiotes
-
Publications
- À propos de l’Institut
Section professionnels de santé
Retrouvez ici votre espace dédié
en_sources_title
en_sources_text_start en_sources_text_end
Chapitres

A propos de cet article
Sommaire
Chapitres
Le saviez-vous ? Nos ancêtres consommaient les ancêtres des probiotiques d’aujourd’hui !1 Dès le Néolithique, ils ont constaté que la fermentation de certains aliments avait des vertus insoupçonnées. Lait, blé ou légumes devenaient plus faciles à conserver, plus savoureux, plus digestes… et meilleurs pour la santé1,2.
A l’aube de l’Antiquité, il y a au moins 5000 ans, les Egyptiens, les Romains et les Hindous appréciaient déjà le lait fermenté2. Quant aux anciens Turcs, ils le considéraient comme un élixir de vie. Est-ce le secret de leur force légendaire ? Trois siècles avant notre ère, les ouvriers chinois construisant la Grande Muraille mangeaient du chou fermenté pour leur bien-être2. De son côté, le célèbre Hippocrate, « père de la médecine » conseillait du fromage aux athlètes olympiques1. Même pour les soldats du terrible Genghis Khan, le lait fermenté était source de force et vigueur pour remporter les batailles !3 Ce n’est qu’à partir du début du 20ème siècle, notamment suite aux travaux de Louis Pasteur, qu’on a découvert que ces vertus provenaient de micro-organismes bénéfiques1.
C’est quoi un probiotique ?
Les probiotiques sont « des micro-organismes vivants qui, lorsqu'ils sont administrés en quantités adéquates, confèrent un bénéfice pour la santé de l'hôte » !4.5. Besoin de sous-titres pour cette version originale d’experts ?
Comme des bactéries ou des levures.
En pleine forme pour agir : des micro-organismes morts ne sont pas probiotiques !
Ni trop, ni trop peu pour agir efficacement et sans danger.
Dans ce cas, les probiotiques ont un effet positif sur la santé de celui ou celle qui les prend6.
Un probiotique, ce n’est pas…
- … un antibiotique, au contraire ! Le terme « probiotique » (pour la vie) a justement été proposé par des chercheurs dans les années 60 pour s’opposer à « antibiotique » (contre la vie)1.
- … un microbiote, qui décrit tous micro-organismes présents dans un environnement donné -comme les intestins. Le microbiome, c’est tout simplement le génome (tous les gènes) de l’ensemble de ces micro-organismes7!
- … un prébiotique, des fibres alimentaires non digestibles particulières qui nourrissent » spécifiquement les bonnes bactéries du microbiote et ainsi, apportent un bénéfice pour la santé8. Quand ils sont ajoutés à des probiotiques dans des produits spécifiques, on les appelle des symbiotiques9.
- … un aliment fermenté, qui est un aliment élaboré avec des micro-organismes vivants choisis et grâce à certaines transformations enzymatiques : yaourt, fromage, choucroute… Même s’il a des vertus pour la santé, un aliment fermenté n’est pas forcément probiotique10.
- … une transplantation de microbiote fécal (TMF), un traitement consistant à soigner le microbiote d’une personne malade en lui transplantant celui d’un donneur en bonne santé. La TMF est aujourd’hui uniquement utilisée en d’infection intestinale récidivante par une bactérie appelée « Clostridioides difficile »11.
Qui sont les micro-organismes probiotiques ?
Familièrement appelés « microbes » ou encore « germes », les micro-organismes sont de des êtres vivants « microscopique » c’est-à-dire qu’il est impossible de les voir à l’œil nu12. Souvent, ils n’ont qu’une seule cellule !
Parmi eux, on compte les bactéries, qui vivent partout dans notre environnement : dans la terre, dans l’eau, et même sur et dans notre corps !12,13 On trouve également les champignons microscopiques : levures (de la levure de boulanger Saccharomyces aux Candida responsables de mycoses) ou moisissures (comme Penicillium, qui donne le « bleu » du Roquefort mais aussi la pénicilline, ce célèbre antibiotique)12,14,15,16. Les virus sont aussi des micro-organismes mais, incapables de survivre sans infecter une cellule, ils ne sont pas toujours considérés comme des « êtres vivants »12,17. Il y a aussi les amibes, les microalgues…18,19 Ce petit monde est gigantesque : il y a un déjà milliard de bactéries dans une petite cuillérée de terre ! Rassurez-vous : plus de 99% d’entre elles sont inoffensives pour nous12,20.
Les micro-organismes les plus utilisés comme probiotiques sont :
- des bactéries issues du microbiote humain ou des produits laitiers fermentés, les
(sidenote:
Lactobacilles
Bactérie en forme de batônnet, dont la caractéristique principale est de produire de l’acide lactique. C’est pour cela que l’on parle de « bactéries lactiques ».
Ces bactéries sont présentes chez l’homme au niveau des microbiotes oral, vaginal, intestinal, mais aussi sur les plantes ou chez les animaux. On peut les consommer dans les produits fermentés : produits laitiers comme certains fromages et yaourts, mais aussi des d’autres types d’aliments fermentés : les cornichons, la choucroute etc..
Les lactobacillus sont aussi consommés dans les probiotiques, certaines espèces étant reconnues pour leurs propriétés bénéfiques.
W. H. Holzapfel et B. J. Wood, The Genera of Lactic Acid Bacteria, 2, Springer-Verlag, 1st ed. 1995 (2012), 411 p. « The genus Lactobacillus par W. P. Hammes, R. F. Vogel
Tannock GW. A special fondness for lactobacilli. Appl Environ Microbiol. 2004 Jun;70(6):3189-94.
Smith TJ, Rigassio-Radler D, Denmark R, et al. Effect of Lactobacillus rhamnosus LGG® and Bifidobacterium animalis ssp. lactis BB-12® on health-related quality of life in college students affected by upper respiratory infections. Br J Nutr. 2013 Jun;109(11):1999-2007.
)
(Lactobacillus) et les
(sidenote:
Bifidobactéries
Bactéries, en forme de batônnet, en Y. La plupart des espèces sont bénéfiques pour l’homme. Elles sont retrouvées dans les intestins de l’homme, mais également certains yaourts.
Ces bactéries :
- Protègent la barrière intestinale
- Participent au développement du système immunitaire, aident à lutter contre l’inflammation
- Favorisent la digestion, améliorent les symptômes gastro intestinaux Sung V, D'Amico F, Cabana MD, et al. Lactobacillus reuteri to Treat Infant Colic: A Meta-analysis. Pediatrics. 2018 Jan;141(1):e20171811. O'Callaghan A, van Sinderen D. Bifidobacteria and Their Role as Members of the Human Gut Microbiota. Front Microbiol. 2016 Jun 15;7:925. Ruiz L, Delgado S, Ruas-Madiedo P, et al. Bifidobacteria and Their Molecular Communication with the Immune System. Front Microbiol. 2017 Dec 4;8:2345. ) (Bifidobacterium)3,21. ; - des levures comme Saccharomyces boulardii, issue la peau des litchis3,15.
Tous sont désignés par un nom latin précis
- Avec d’abord leur genre, par exemple Lactobacillus,
- Ensuite leur espèce au sein de ce genre, ce qui donne par exemple Lactobacillus « acidophilus »,
- Et enfin, leur souche au sein de cette espèce, sous forme d’une suite de lettres et/ou de chiffres qui tel un code-barres indique et identifie précisément le microorganisme. La souche distingue les particularités génétiques de chaque espèce de micro-organisme. C’est elle qui rend chaque probiotique unique !21
Par exemple Lactobacillus acidophilus XYZ123.
Vous en perdez votre latin ?
Pensez à une salade de fruits avec prunes, cerises, pêches et nectarines. Tous viennent du même genre d’arbre, le Prunus ! L’espèce Prunus avium donne par exemple des cerises et Prunus persica donne des pêches - dont il existe encore des centaines de variétés : jaunes, blanches, lisses ou duveteuses, rondes ou plates !22.
Comment sont choisis les probiotiques ?
Trouver les « heureux élus » parmi les milliards d’espèces de micro-organismes : dure tâche pour les chercheurs ! C’est peut-être pour saluer leurs efforts que les espèces probiotiques portent souvent leur nom : Saccharomyces boulardii a ainsi été isolé par Henri Boulard23 et Lactobacillus reuterii (dont le nouveau nom est Limosilactobacillus reuteri24) par Gerhard Reuter25.
Qu’elles proviennent du lait, des fruits ou du corps humain, les espèces de micro-organismes potentiellement bénéfiques sont étudiées sous toutes les coutures de façon à trouver les souches les plus intéressantes.
- Première étape, on les identifie, suivant les caractéristiques de leur génome. Les microorganismes sont classés. On leur attribue un nom avec un numéro de souche4,26.
- Deuxième étape, on réduit peu à peu les candidats potentiels en fonction de leurs propriétés bénéfiques comme des actions anti-pathogènes, anti-cholestérol ou encore régulateur du transit intestinal4,26…
- Troisième étape, on vérifie leur innocuité, c’est-à-dire qu’ils sont sans danger pour la santé ; les chercheurs regardent alors s’ils n’ont pas gènes de résistances aux antibiotiques, de toxine ou ne provoquent pas d’effets indésirables mais aussi si les candidats probiotiques sont capables de survivre dans certaines conditions extrêmes comme le milieu intestinal (température, pH, acides biliaires…)4,26.
- Quatrième étape, et non des moindres, on valide l’efficacité du probiotique chez l’homme on parle alors d’« essais cliniques » qui devront suivre les recommandations précises des autorités de santé (locales/nationales). C’est à ce stade que le microorganisme testé peut être qualifiées de probiotique4,26.
- Dernière étape, on s’assure que le probiotique est vivant et à la dose efficace tout au long de la durée vie du produit. Les probiotiques sont ensuite déposés dans une « banque internationale de souches microbiennes »4,27.
A quoi servent les probiotiques ?
Notre organisme compte plusieurs microbiotes. Le plus important se trouve dans les intestins (c’est la « flore intestinale »), mais il y a aussi un microbiote de la peau, du vagin, de la bouche, des voies respiratoires28,29… Dans ces microbiotes, des milliards de micro-organismes travaillent en harmonie28,30. La plupart sont inoffensifs ou bénéfiques à la santé31. Certains sont potentiellement pathogènes, autrement dit pourraient provoquer des maladies, mais leur développement est freiné par les micro-organismes « amies »32. Pour différentes raisons, comme une alimentation pas assez saine, un stress, une maladie ou une prise d’antibiotiques, l’équilibre du microbiote peut se rompre : on parle de « (sidenote: Dysbiose La « dysbiose » n’est pas un phénomène homogène : elle varie en fonction de l’état de santé de chaque individu. Elle est généralement définie comme une altération de la composition et du fonctionnement du microbiote, provoquée par un ensemble de facteurs environnementaux et liés à l’individu, qui perturbent l’écosystème microbien. Levy M, Kolodziejczyk AA, Thaiss CA, et al. Dysbiosis and the immune system. Nat Rev Immunol. 2017;17(4):219-232. ) »28,30. La composition du microbiote est altéré, il s’appauvrit, les micro-organismes bénéfiques sont moins abondants, et les pathogènes en profite pour coloniser l’espace et se multiplier33…
En venant « en renfort » dans le microbiote, les probiotiques peuvent aider celui-ci à maintenir ou retrouver son équilibre, agir sur notre système de défense immunitaire en diminuant l’inflammation, nous protéger en s’attaquant aux (sidenote: Pathogène Un pathogène est un microorganisme qui cause, ou peut causer, une maladie. Pirofski LA, Casadevall A. Q and A: What is a pathogen? A question that begs the point. BMC Biol. 2012 Jan 31;10:6. ) ou leurs toxines. Et ainsi, à prévenir ou corriger les troubles et maladies liés à une dysbiose34,35,36. Cependant, selon les souches, les probiotiques ont des modes d’action différents, un effet bénéfique spécifique ne pourra pas être extrapolable d’une souche à une autre37.
Pourquoi prendre des probiotiques ?
Quel bénéfice ? Qu’est-ce que cela m’apporte ?
Les bénéfices des probiotiques sur notre santé sont nombreux. Cependant, suivant l’efficacité que chacune des souches de probiotique a démontré dans des études sur l’homme, ils ont prouvé leur intérêt dans des situations bien précises5,38 :
- Troubles de l’appareil digestif comme les diarrhées dues aux antibiotiques39, les diarrhées à C. difficile40, les gastro-enterites41, les diarrhées du voyageur (ou « touristas »)42, troubles fonctionnels intestinaux (ou « intestin irritable »)43,44, les troubles de la digestion du lactose21, les maladies inflammatoires des intestins (MICI)45…,
- Infections respiratoires hivernales46,
- Maladies cutanées47,
- Infections urinaires48,
- Infections vaginales49.
Comment sont fabriqués les probiotiques ?
La fabrication des probiotiques exige la maîtrise d'un procédé technique délicat et des contrôles stricts répétés à chaque étape de la chaîne de production. Elle doit en effet garantir au consommateur un produit fini répondant à toutes les normes de qualité et de sécurité. Les micro-organismes probiotiques doivent rester vivants, en nombre suffisant et stable jusqu'à la fin de la durée de conservation du produit, être correctement dosés pour le bénéfice annoncé et être exempts de contaminants5,6,51.
Cette infographie est une représentation simplifiée et non exhaustive d’un processus de sélection puis de fabrication de probiotiques avec des exemples théoriques de point de contrôle.
Les différentes étapes de fabrication6,52:
Ce processus par étape est un exemple simplifié et non exhaustif de fabrication de probiotiques.
Le micro-organisme sélectionné est mis en culture avec des substances nutritives stérilisées afin qu’il se multiplie.
Cette première culture est transférée dans des (sidenote: Fermenteur Appareil ou cuve dans lequel sont multipliés des micro-organismes selon des conditions de culture contrôlées. Mustafa MG, Khan MGM, Nguyen D, et al. (2018) Omics Technologies and Bio-engineering: Volume 2: Towards Improving Quality of Life, , pp. 233-249. ) successifs (de taille moyenne, puis plus grands) pour une production industrielle. Les conditions de croissance et l’absence de (sidenote: Contaminant Substance indésirable, impureté (micro-organismes pathogènes, résidus…) Motarjemi Y, Moy GG, & Todd EC (2014). Encyclopedia of food safety. ) doivent être étroitement contrôlées.
Après leur multiplication, les micro-organismes sont séparés de leur milieu de culture par centrifugation ou filtration.
La pâte obtenue contenant les microorganismes va ensuite subir une congélation rapide puis une déshydratation pour en extraire l'eau, c’est la lyophilisation qui va permettre d’évaporer au moins 96%53 de l’humidité restante. Ainsi les micro-organismes se conservent mieux tout en restant vivants.
Ce « gâteau sec » obtenu après lyophilisation est broyé en fine poudre pour être mélangé (suivant le process de production du fabricant) à des (sidenote: Excipient Substance ajoutée à un principe actif pour améliorer l'aspect, le goût, la conservation d’un médicament, ou encore pour faciliter sa mise en forme ou son administration. Cha J, Gilmor T, Lane P, Ranweiler JS. Ch.12 Stability Studies (2011) in Handbook of Modern Pharmaceutical Analysis. Separation Science and Technology, 10 (C), pp. 459-505. ) .
La poudre est ensuite conditionnée dans son format définitif (gélules, sachets, ampoules...). Le choix et la qualité du format utilisé doit permettre d’augmenter la stabilité du produit. Ils sont enfin emballés dans leur contenant final ou boite.
Les probiotiques empaquetés sont stockés dans des environnements contrôlés (température, humidité…).
Ils sont enfin livrés sur leur point de vente, par exemple en pharmacie.
A chaque étape de la production - voire même plusieurs fois au cours d’une même étape - des contrôles doivent être réalisés sur les échantillons pour vérifier que le produit est conforme, c’est-à-dire que la qualité et la pureté sont optimales6. Il est nécessaire que les micro-organismes soient toujours vivants et sans danger pour leur consommation6. Pour que les consommateurs puissent avoir le maximum de confiance dans la qualité de leurs produits, certains laboratoires ont recours, en plus de leurs propres contrôles, à des organismes extérieurs et indépendants qui vérifient que l’ensemble des processus de fabrication et de contrôle qualité sont conformes à la réglementation et aux bonnes pratiques27.
Pas si simple de faire son choix parmi les nombreux probiotiques existants, comme vous l’avez vu, tous les probiotiques ne sont pas identiques. Et aucun d’entre eux, souche ou combinaison de souches probiotiques, n'aura en même temps tous les effets bénéfiques décrits ici50. Demandez conseil a votre médecin ou votre pharmacien, il vous recommandera les produits dont vous avez besoin en fonction de votre état de santé.
L'Observatoire International des Microbiotes
Que nous réserve la science ?
Depuis plusieurs années, la recherche sur le microbiote humain et les probiotiques est en pleine effervescence. Stimulée par les progrès technologiques de la biologie, elle nous apporte de nouvelles connaissances scientifiques, parfois surprenantes, sur les interactions fines et complexes au sein des écosystèmes microbiens. Probiotiques de précision, micro-ARN, consortia de probiotiques, postbiotiques… La recherche ouvre la voie à des propositions inédites et prometteuses pouvant répondre, aujourd’hui et demain, aux besoins de santé de chacun d’entre nous.
La science nous a déjà livré quelques-uns des secrets de l’action des probiotiques sur notre santé. On sait aujourd’hui que l’effet bénéfique d’un probiotique est à la fois dépendant de la souche et de certaines caractéristiques de l’individu qui le consomme comme son âge, son alimentation, son état de santé, ses traitements médicamenteux mais aussi son microbiote 54. Cet effet peut donc varier entre les personnes 55. Ces dernières années, des avancées scientifiques majeures ont été réalisées dans la compréhension des interactions entre les microbiotes et le corps humain. Elles suggèrent que la modulation de ces écosystèmes microbiens pourrait apporter des solutions nouvelles à de grands enjeux de nutrition et de santé 56.
Alors comment faire en sorte que les probiotiques de demain soient à la fois plus efficaces, plus ciblés et mieux adaptés au microbiote de chacun ? De nombreuses équipes scientifiques se sont déjà engagées dans ce vaste champ de recherche. Leurs armes pour le défricher :
- Les disciplines « -omics » de la biologie d’aujourd’hui.
(sidenote: Génomique Etude de l’ensemble des gènes d’un être vivant (génome), y compris les interactions entre les gènes et avec leur environnement. https://www.genome.gov/about-genomics/fact-sheets/A-Brief-Guide-to-Genomics ) , (sidenote: Transcriptomique Etude de toutes les molécules d'ARN dans une cellule. L'ARN est copié à partir de morceaux d'ADN et contient des informations pour fabriquer des protéines et remplir d'autres fonctions importantes dans la cellule. La transcriptomique est utilisée pour en savoir plus sur la façon dont les gènes sont activés (leur régulation, leur expression) dans différents types de cellules. https://www.cancer.gov/publications/dictionaries/cancer-terms/def/transcriptomics https://www.nature.com/subjects/transcriptomics ) , (sidenote: Protéomique Etude des protéines présentes dans une cellule, un tissu ou un organisme (protéome) ou de la structure et du fonctionnement d’une protéine. https://academic.oup.com/chromsci/article/55/2/182/2333796 ) , (sidenote: Métabolomique Etude de l’ensemble des métabolites, substances générées par les processus biologiques au cours du métabolisme, elle permet d’en obtenir l’empreinte chimique spécifique. Clish CB. Metabolomics: an emerging but powerful tool for precision medicine. Cold Spring Harb Mol Case Stud. 2015;1(1):a000588. ) , 56…. Ensemble, ces disciplines couvrent l’ensemble des processus et des échanges cellulaires impliqués dans le fonctionnement d’un système de l’organisme, comme le microbiome humain. Quant à la (sidenote: Bioinformatique Analyse des données biologiques par ordinateur Cunningham M, Azcarate-Peril MA, Barnard A et al. Shaping the Future of Probiotics and Prebiotics. Trends Microbiol. 2021;29(8):667-685 ) , elle permet de traiter les énormes volumes de données que ces nouveaux outils génèrent.
- L’identification des organismes clés du microbiote :
Les connaissances scientifiques apportées par ces nouvelles méthodes permettent aux chercheurs de comprendre beaucoup plus finement l’organisation du microbiote : comment il fonctionne, comment les microorganismes interagissent entre eux et avec l’individu qui les héberge 56… L’objectif ? Identifier les microorganismes clés pour son équilibre. Les chercheurs peuvent ainsi isoler des souches spécifiques et ciblées selon leurs bénéfices potentiels sur le microbiote et la santé. Ils peuvent aussi observer le mode d’action de ces futurs probiotiques au cœur de leurs cellules, leurs interactions avec le microbiote et la réponse de l’hôte 54,57.
Les probiotiques « de nouvelle génération »
Ces nouvelles approches scientifiques et technologiques ont permis l’émergence de probiotiques dits (sidenote: Probiotiques « de nouvelle génération » Microorganismes vivants identifiés sur la base d’analyses comparatives du microbiote et qui lorsqu’ils sont administrés en quantités adéquates, sont bénéfiques à la santé de l’hôte. Martín R, Langella P. Emerging Health Concepts in the Probiotics Field: Streamlining the Definitions. Front Microbiol. 2019;10:1047. ) . Parmi les plus récemment identifiés figurent Roseburia intestinalis, Faecalibacterium prausnitzii, Akkermansia muciniphila… Issues de ces espèces importantes pour le microbiote humain, ces souches agiraient sur des processus physiologiques (métabolisme, immunité) qui ne seraient pas forcément atteints par les probiotiques classiques 56, mais aussi sur certains mécanismes pathologiques précis intervenant par exemple dans les cancers, l’obésité, le diabète, les maladies cardiovasculaires, inflammatoires, auto-immunes, la douleur… 56,58,59,60 . Elles pourraient ainsi entrer dans le cadre des (sidenote: Produit ou agent biotherapeutique Produit biologique contenant des organismes vivants, comme des bactéries, et destiné à prévenir ou traiter des troubles ou maladies (les vaccins n'entrent pas dans cette catégorie). Rouanet A, Bolca S, Bru A, et al. Live Biotherapeutic Products, A Road Map for Safety Assessment. Front Med (Lausanne). 2020;7:237. ) , c’est-à-dire des médicaments contenant des organismes vivants. Les probiotiques de nouvelle génération sont en premier lieu des souches jamais utilisées auparavant. Mais il peut également s’agir de probiotiques connus mais qui seront génétiquement modifiés pour produire des molécules spécifiques d’intérêt comme des acides gras à chaîne courte (AGCC), pour augmenter leur survie dans le tube digestif ou encore pour améliorer leur métabolisme, leur propriétés immunomodulatrices, leur capacité à combattre certains pathogènes, etc... 60
Des probiotiques de précision pour une médecine personnalisée
L’ère des « probiotiques de précision » est donc déjà en marche. Et prenant l’avantage sur la variabilité de la réponse de l’hôte, celle des probiotiques personnalisés s’annonce ! En effet, le concept de médecine personnalisée reposant sur la prise en compte des spécificités de chaque patient pour vaincre la maladie, les probiotiques « nouvelle génération » peuvent naturellement s’intégrer dans cette approche par leurs capacités à moduler le microbiote de l’hôte en fonction de ses caractéristiques. 54
Les chercheurs imaginent aujourd’hui des moyens d’analyser le microbiote intestinal de toute personne pouvant bénéficier d’un probiotique afin de déterminer préalablement le plus adapté. La mise au point de dispositifs miniaturisés à ingérer avec prélèvement d’un échantillon de la flore afin de le caractériser est déjà envisagée. Les scientifiques estiment également que grâce à la démocratisation médicale du séquençage à haut débit, chacun d’entre nous pourrait bientôt disposer du génome de son microbiote et ainsi obtenir des recommandations « sur-mesure » pour rester en bonne santé grâce à la nutrition, aux probiotiques ou aux prébiotiques. 54
Des applications nouvelles de santé publique
Les probiotiques sont aujourd’hui explorés pour répondre à des enjeux de santé publique, en particulier pour des situations où les options thérapeutiques classiques deviennent insuffisantes. Par exemple, face à l’augmentation inquiétante des antibiorésistances dans le monde, des probiotiques aux activités antimicrobiennes ou immunomodulatrices sont étudiés en tant qu’alternative aux antibiotiques. Le potentiel thérapeutique des probiotiques dans d’autres problèmes de santé importants comme l’obésité, les maladies du foie, les problèmes de la fertilité, l’excès de cholestérol ou les troubles de l’humeur, est également testé 56 . Enfin, les probiotiques contribueraient à améliorer la prise en charge des cancers : par exemple, certaines souches semblent optimiser les traitements (et/ou réduire leur toxicité) des cancers du côlon, des poumons, des reins… 60,62 .
Zoom sur un acteur révélé par la transcriptomique : les microARNs
Découverts dans les années 90, les microARNs intéressent vivement les chercheurs : ces régulateurs fins de l’expression des gènes participent à de nombreux processus cellulaires. Leurs dysfonctionnements engendrant de nombreuses maladies, y compris des cancers 63 , ils sont aujourd’hui explorés en tant que cibles thérapeutiques 64 . Les microARNs régulent également les interactions entre les cellules de l’organisme et les microorganismes du microbiote. Or les probiotiques apparaissent capables de modifier leur expression, par exemple lorsque celle-ci est associée à une inflammation intestinale. La possibilité d’agir sur les microARNs par des probiotiques afin d’équilibrer le microbiote et de traiter certaines pathologies, notamment digestives, est très prometteuse 65 .
Un pouvoir probiotique décuplé : les consortia
Les probiotiques changent aussi de visage : les scientifiques les expérimentent en groupe… ou en morceaux ! En effet, l’équilibre du microbiote dépend des interactions entre ses microorganismes et plusieurs espèces peuvent être anormalement sous-représentées en cas de dysbiose. Inspirés par les succès de la (sidenote: Transplantation fécale Cette approche thérapeutique consiste à introduire les selles d’une personne saine dans le tube digestif d'un patient afin de reconstituer sa flore intestinale. Pour le moment, elle n’est autorisée que pour le traitement des infections récurrentes à Clostridioides difficile. Quigley EMM, Gajula P. Recent advances in modulating the microbiome. F1000Res. 2020;9:F1000 Faculty Rev-46. ) qui intègre tout un écosystème bactérien, des chercheurs testent donc actuellement des consortia de probiotiques : des formulations de plusieurs souches agissant en « réseau » et en synergie 56 pour un effet thérapeutique défini 66 .
Avez-vous déjà entendu parler des postbiotiques ?
Des post bio…quoi ? Des postbiotiques ! 67 Ce ne sont pas des microorganismes entiers vivants comme doivent l’être les probiotiques, mais des fragments microbiens, des souches inactivées (la cellule est morte et ne se multiplie plus) ou des métabolites bactériens (protéines, enzymes…) capables d’apporter des bénéfices à l’hôte. Avantageux par leur facilité de production et de conservation, ils montreraient certains effets similaires, voire supérieurs, à leurs homologues probiotiques 56,68 . Des études doivent être menées pour confirmer ces premiers résultats encourageants.
Bactériophages : des virus tueurs de bactéries …
Mais ce n’est pas tout : les recherches sur les traitements par les phages, des virus attaquant spécifiquement certaines bactéries pathogènes du microbiote, reprennent après des décennies de mise en sommeil. De récents travaux suggèrent que les phages pourraient entrer dans l’arsenal thérapeutique des infections multirésistantes. Ils pourraient aussi contribuer à la correction de dysbioses associées à certaines maladies ou encore servir de « moyen de transport » pour des médicaments ciblés. Là aussi, des travaux scientifiques et des essais cliniques sont nécessaires avant que la phagothérapie puisse faire partie de nouvelles options efficaces et sûres pour la médecine de demain 69 .
Partez à la découverte des microbiotes !

Recommandé par notre communauté

"C'est tout à fait vrai" - Commentaire traduit de Farida Persaud (Repris de My health, my microbiota)
"Merci pour ces informations si importantes !" - Commentaire traduit de Sylvie Lalonde (Repris de My health, my microbiota)
11 Zallot, Camille : Transplantation de microbiote fécal et pathologies digestives, La Lettre de l'Hépato-gastroentérologue, Vol. XXI -n° 1, janvier-février 2018.
13 Site Web Microbiology Society : Bacteria (accédé le 05/06/21).
14 Site Web Microbiology Society : Fungi (accédé le 05/06/21).
17 Site Web Microbiology Society : Viruses (accédé le 05/06/21).
18 Site Web Microbiology Society : Algae (accédé le 05/06/21).
19 Site Web Microbiology Society : Protozoa (accédé le 05/06/21).
20 “Microbiology by numbers.” Nature reviews. Microbiology vol. 9,9 (2011): 628.
22 https://jardinage.lemonde.fr/dossier-212-cerisier-prunus-cerasus.htm
28 Site Web Inserm : Microbiote intestinal (flore intestinale) (MAJ 01/02/16, accédé le 06/06/21).
29 Beck JM, Young VB, Huffnagle GB. The microbiome of the lung. Transl Res. 2012;160(4):258-266.
31 Normal Microbiota and Host Relationships. 3 Jan. 2021
32 McFarland LV. “Normal flora: diversity and functions”. Microb Ecol Health Dis 2000;12:193–207
38 Williams NT. Probiotics. Am J Health Syst Pharm. 2010;67(6):449-458.